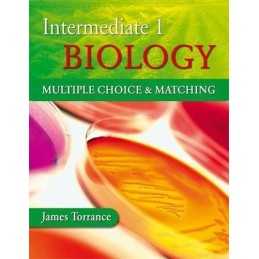
Intermediate 1 Biology Multiple Cho..., Torrance, James

Shackleton (A Ladybird Expert Book) (The Ladybird Expert Ser... by Saunders, Ben
Hea seisukord - Raamat, mis on loetud, kuid heas seisukorras. Raamatukaanel on minimaalne kahjustus. Suurem osa lehekülgi on kahjustamata, võib esineda kortsude või rebenditega ning teksti pliiatsiga allajoonimisega. Veeristele ei kirjutata, puuduvad leheküljed.
18,49 €